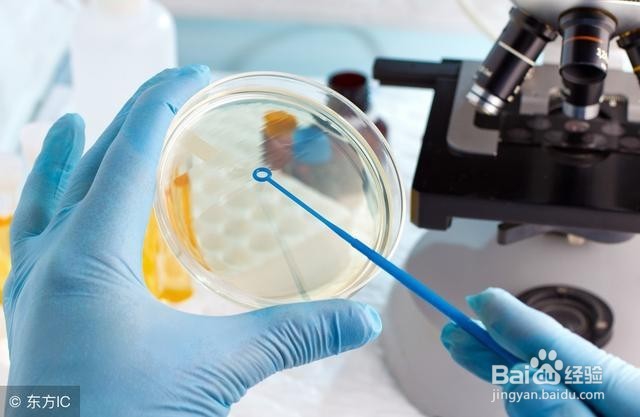

什么是颅内感染
1、什么是颅内感染?
颅内感染是中枢神经系统较为严重的疾病之一,多由于细菌、病毒、寄生虫、支原体、衣原体、霉菌、立克次体等病原体随着血液循环,经过血脑屏障,侵入到中枢神经系统即颅脑内,产生一系列症状,称为颅内感染;包括脑炎、脑膜炎和脑脓肿。
2、颅内感染的临床表现?
可发生于任何年龄段,潜伏期一般为2~21天,平均一周;前驱期可有发热、全身不适、嗜睡、四肢酸痛等症状。急性起病。脑炎患者多表现为脑实质损害症状,出现抽搐、失语、精神异常、智力障碍、肢体偏瘫、甚至昏迷。脑膜炎,因侵袭脑膜,主要表现为头痛、呕吐、颈强直和脑膜刺激征。脑脓肿除有以上发热等感染症状外,多因脓肿不同部位占位产生局灶性脑损害的表现。严重病例或延误治疗的病人,可出现大面积脑实质感染、炎性脑水肿,甚至脑干感染,死亡。
3、颅内感染如何诊断?
详细询问病史,并进行全面的体格检查,如果怀疑颅内感染,应进行腰穿留取脑脊液检查,明确脑脊液内具体病原菌。这里应注意,因为脑脊液细菌培养假阴性较常见,故一次脑脊液检查结果如果是阴性,可多次留取脑脊液培养。另外,结核性脑膜炎因在脑脊液内很难查到病原菌,这就要求医生对患者的病情进行全面了解、并根据自己的经验及脑脊液常规、生化、压力及头CT、MRI片子进行综合评估来判断。
1、颅内感染能治疗好吗?
颅内感染是一种复杂、治疗难度较大的疾病,可能因病毒性感染、心肌性感染、真菌性感染,或结核性感染引起,也可由开颅手术或颅内置入异物引起。此类疾病治疗相对比较困难,但只要积极采取正确的治疗,绝大多数还是能够恢复的,是可以最终治愈的,因此没有必要过于担心。

2、脑积水是临床神经外科常见疾病,治疗的经典方法为脑室腹腔分流术。
但此类手术术后易出现分流感染。航空总医院脑脊液科陈红伟在临床发现许多地方医院,一旦术后出现不能解释的高热、颈强直、患者意识障碍、腹胀、甚至再次出现术前的脑积水等症状时,多数医院并不在意,其实这时就应该引起高度注意,并根据情况及时留取脑脊液进行培养、常规、生化等检查。同时选用易透过血脑屏障的广谱抗生素。一旦脑脊液培养出病原菌,或者患者病情进行性加重,应及时取出体内分流管、并进行脑室外引流治疗。
这里需要特别指出的是,因脑脊液培养存在假阴性情况,就是很多情况下,有颅内感染、但脑脊液培养无细菌生长,所以不能一味等待脑脊液培养,而耽误了治疗,临床中症状和体征一定是最关键的,其他都是辅助判断的。
多数患者经过一段时间脑脊液专科抗感染治疗后,发热等症状消失,连续三次脑脊液培养无细菌生长,脑脊液常规、生化达到正常后,表明颅内感染得到最终治愈。
对于病毒性脑炎及结核性脑膜炎、真菌性脑膜炎,根据不同的病原菌采取不同的脑脊液专科抗感染治疗方法,一般都能得到比较满意的效果。当然,如果颅内感染发现、治疗不及时,或者治疗方法错误,导致病情进行性发展,最终会因为病原菌侵袭脑组织、甚至脑干,危及生命。
所以,颅内感染并不可怕,可怕的是耽误了最佳的治疗时机,如果能及时采取正确的治疗方法,多数患者可获得治愈。